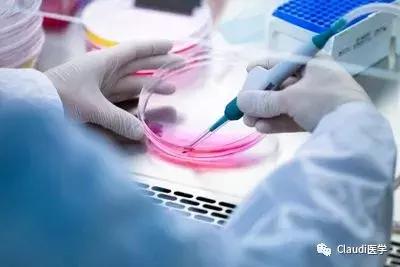
糖尿病急需干细胞突破,治疗糖尿病有最新科技突破吗

文 | 油酱

中国糖尿病世界第一,从人数和发病率都是首位,这个第一我们拿了很多年。
根据研究调查:有将近12%的中国成年人,约(1.139亿)人患有糖尿病。
也就是说每100个中国人里,就有12人患有糖尿病。
很多人不知道我国是名副其实的糖尿病第一国,不过很多中国患者一是不知道自己得了糖尿病,二是一直持有无所谓的态度,没有治疗。
由于我们饮食结构、生活方式等因素,全球糖尿病发病率增长迅速。
糖尿病已成为继肿瘤、新血管病变之后第三大严重威胁人类健康的慢性疾病。
据世界卫生组织统计,到2025年全球成人糖尿病患者人数将达到4000万,未来50年内糖尿病仍将是中国一个严重的公共卫生问题。
尽管中国糖尿病发病趋势严峻,但防治状况不容乐观。
主要原因是国内专业糖尿病治疗机构、人员设备等资源不足。
据统计,我国糖尿病专科医生仅约1万多人,而在2001年的糖尿病确诊率中仅为15%,治疗率77%。
其次,许多中国患者对糖尿病防治知识认知不足,在治疗方面不及时、用药选择不当,致使治疗效果并不理想。

糖尿病是慢性病中最为普遍的一种疾病,其危害主要体现在并发症上。
随着时间的推移,糖尿病的并发症危害就愈发明显,严重影响患者生活。

虽然刚开始可能不易察觉,但病情逐渐发展下去便可能造成失明、心脏病、中风等等。
在过去糖尿病高发人群年龄段在55岁左右,但如今却越来越趋于年轻化。
糖尿病分为一型和二型,一型以年轻人多发型糖尿病;二型主要发病人群在40岁以上。
专家指出:40-59岁正是社会的劳动力主体,这个年龄段的糖尿病患者大量增加,对家庭和个人都会造成很大伤害。
北大教授曾在以《干细胞技术治疗糖尿病》为题的分享中说道:
糖尿病是威胁人类健康的主要疾病之一,中国的糖尿病占全球的三分之一。
可根据调查显示,截止到2013年中国糖尿病患者的治疗率只有1/3,而控制率不足50%。
世界卫生组织预测,2030年糖尿病将成为人类第七位主要死因。
目前,糖尿病现有的治疗方式有胰岛素的注射,但却无法做到根治糖尿病。
胰岛移植可以从身体上调节血糖,但是免疫排斥这些都是问题。
所以,糖尿病也没有很好的根治办法。

但是我们人体有一种细胞,它可以生产出人体任何一种的细胞,这便是干细胞。
干细胞目前被公认为糖尿病治疗根治的希望,科普中国的发布也盖章了这一点,并提出我们应该更重视间充质干细胞的潜力。
间充质干细胞可以分泌多种免疫调节因子和营养因子,来恢复和修复各种受损组织。
由于易于分离,和具有较低的免疫原性,间充质干细胞是目前临床上应用最广泛的干细胞。
同时,糖尿病并发症也是干细胞重点研究攻克的方向。
有关干细胞治疗糖尿病的研究已经进行了多年,从研究结果上来看,干细胞治疗能够起到非常好的效果。
对于糖尿病并发症,部分研究表现出良好的治疗结果。
韩国科学家日前发表一项研究成果显示:
将人体干细胞移植到患有糖尿病的白鼠体内,干细胞能够分泌胰岛素,进而治愈糖尿病。
这一成果证实了利用干细胞治疗人类糖尿病的可能性。
研究人员表示,利用人体干细胞治疗白鼠糖尿病的实验此前获得过成功,但是产生疗效的主要机理是人体干细胞对白鼠胰脏再生的刺激作用。
研究人员相信,此次实验成功应是全球首例。
目前,利用干细胞攻克糖尿病,同时抑制并发症的临床研究正在广泛开展。
我们相信将会有更多的糖尿病患者因此受益,更相信干细胞移植能够给患者们带来疾病的真正逆转。